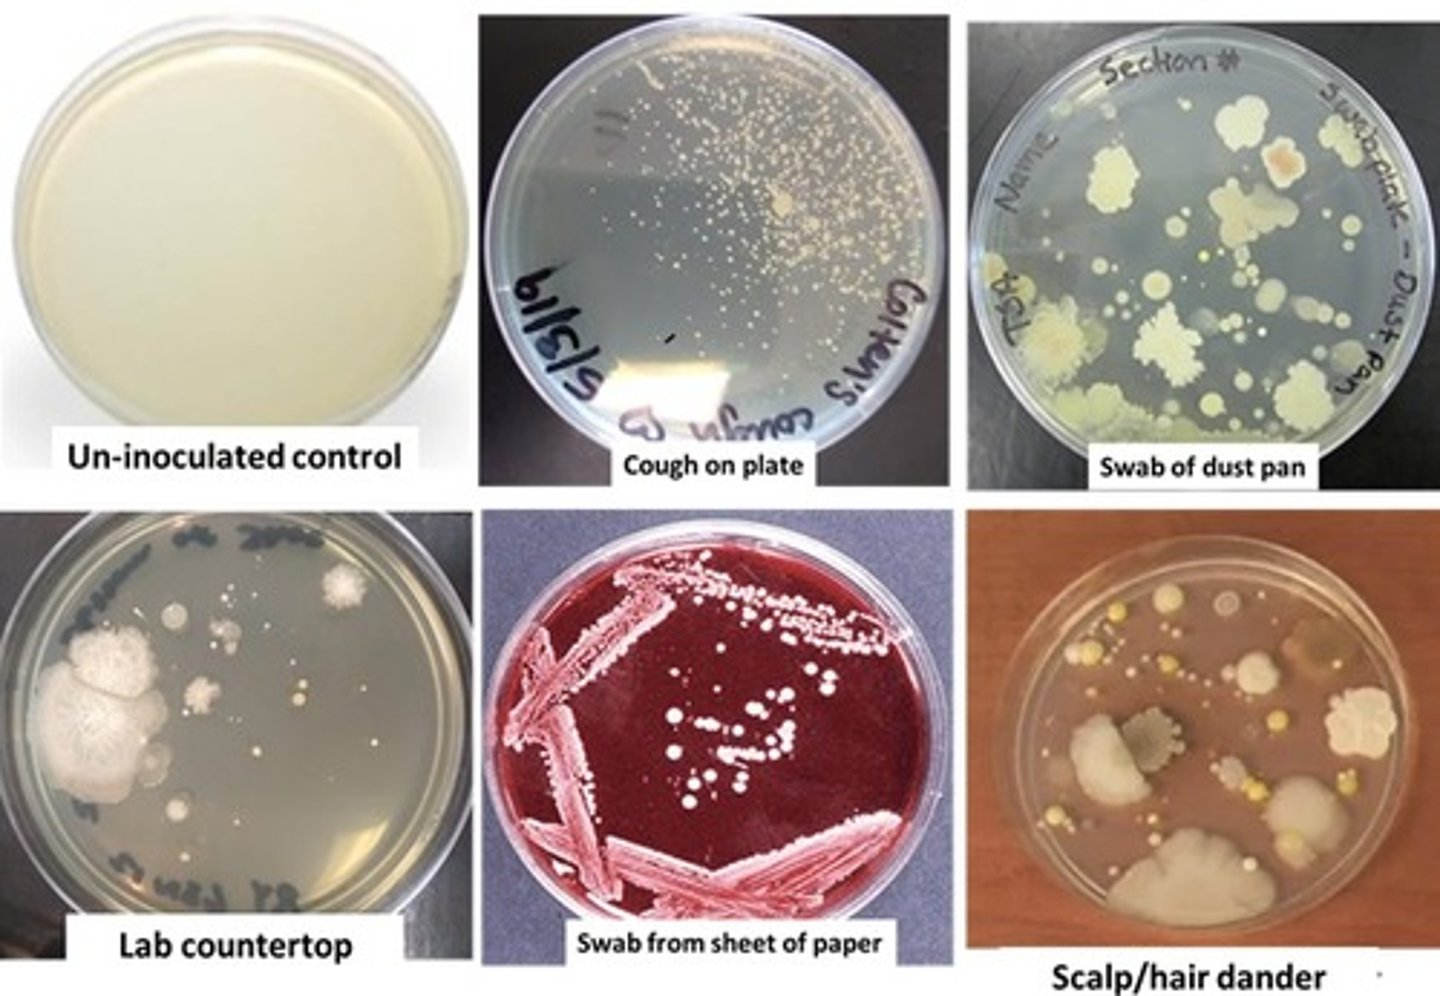
<p>The results of lab exercise 2-1 shown below are, among others, the reason why</p><p>a. hand washing is important</p><p>b. Disinfecting lab countertop is needed</p><p>c. Aseptic techniques were discovered</p><p>d. All of above</p>
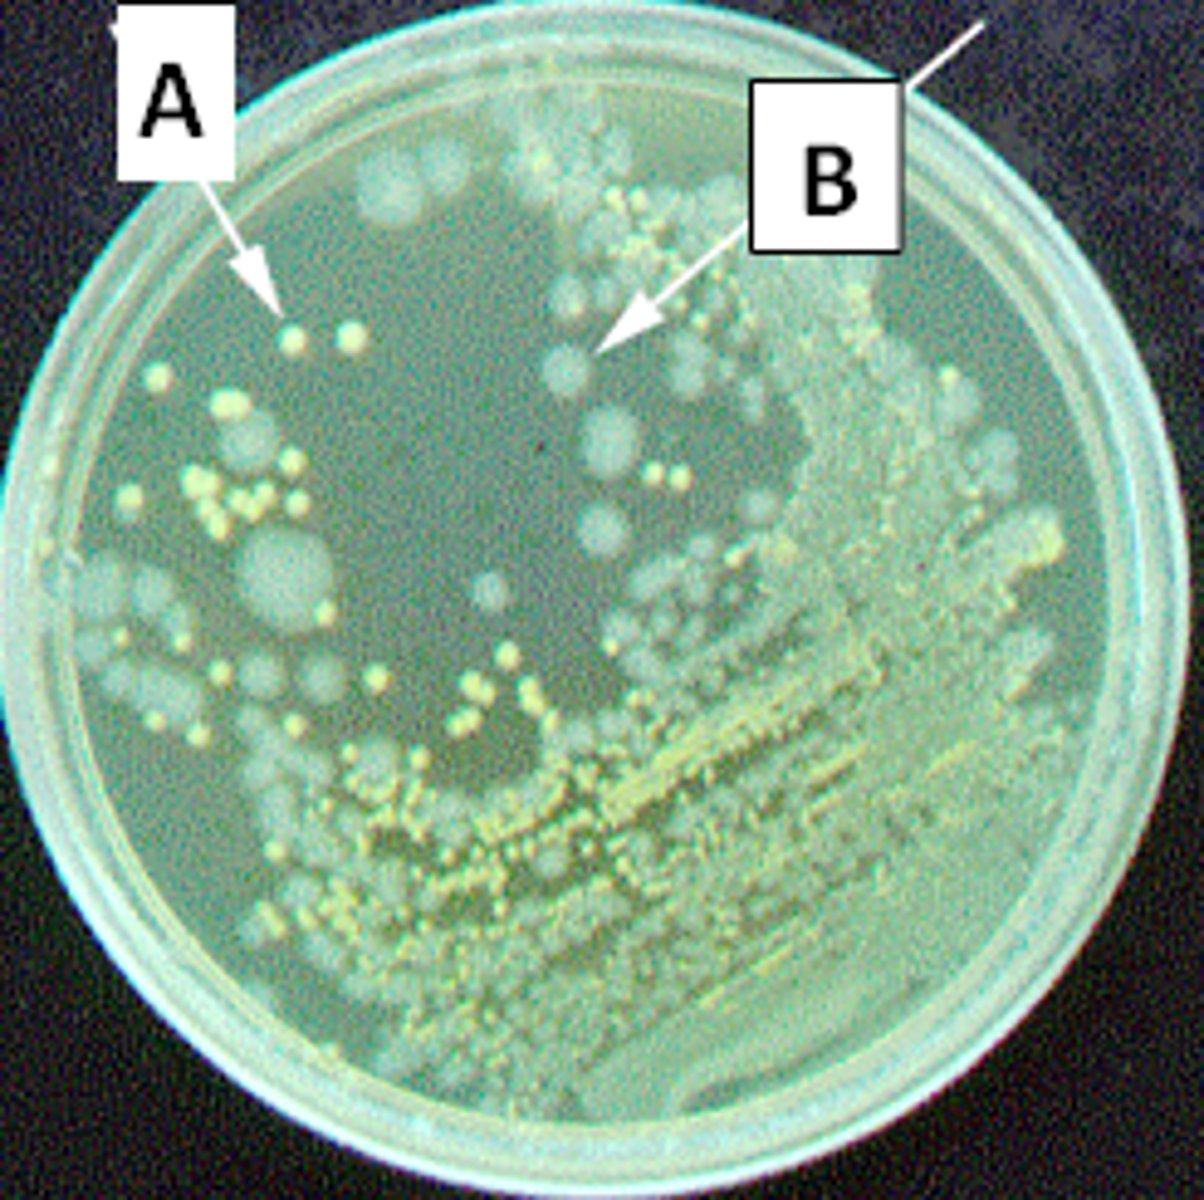
<p>An environmental (soil) sample obtained from a temperate region was transferred to a liquid growth medium and incubated at 30°C for 24 hours, then transferred to solid growth medium in order to isolate bacteria from the original sample. Following 48 hour incubation at 30°C, the picture of the solid medium shows the results of this experiment. Which of the following statement(s) among A - C are true regarding this experiment?</p><p>A. This plate represents a pure culture.</p><p>B. Isolates A and B are likely the only bacterial types that would have been present in the original environmental sample.</p><p>C. A and B are the same organism</p><p>E. NONE of A - C are correct </p>
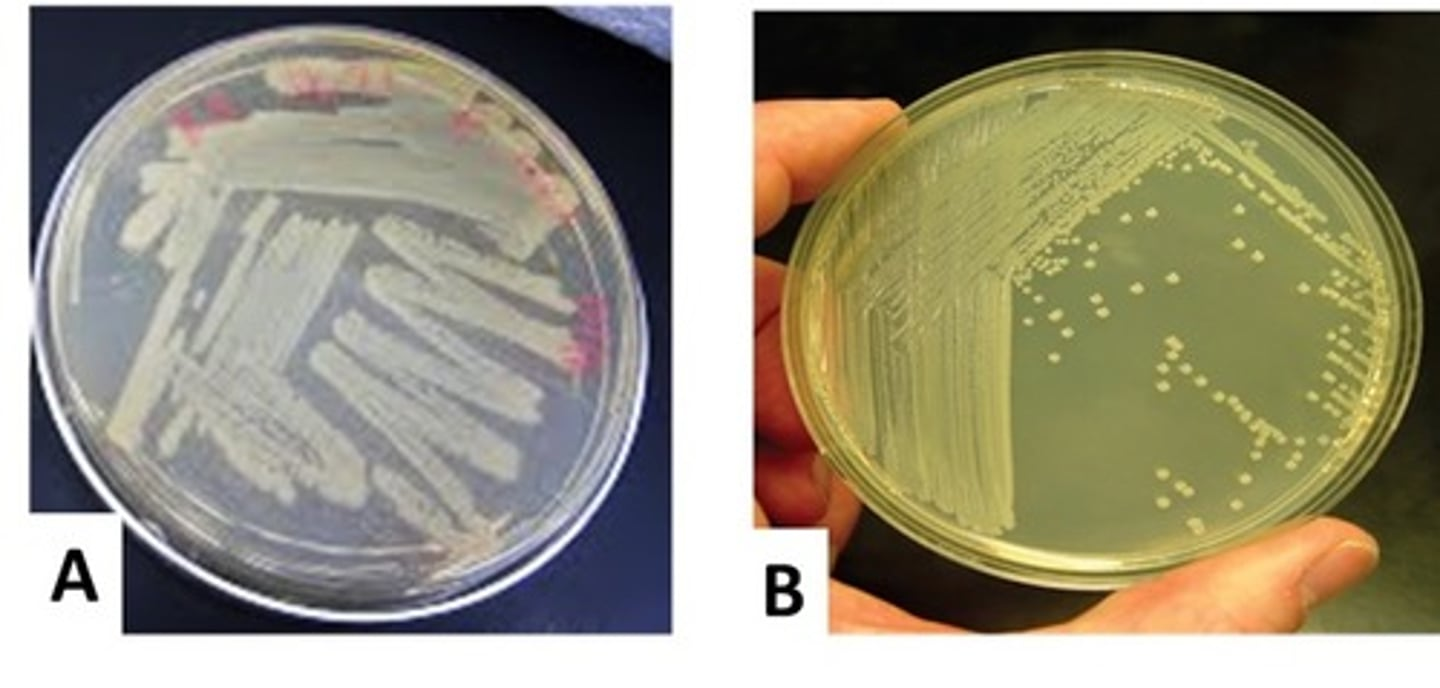
<p>If you performed a quadrant streak plate and obtained the result shown in "A" rather than the desired result shown in "B", then you probably...</p><p>A. forgot to inoculate each new quadrant with fresh culture.</p><p>B. forgot to flame the wire inoculation loop between quadrant streaks</p><p>C. forgot to streak into the previous quadrant.</p><p>D. used the wrong culture for streaking the plate.</p><p>E.forgot to streak with your loop in one continuous motion.</p>

1/480
Looks like no tags are added yet.
Name | Mastery | Learn | Test | Matching | Spaced | Call with Kai |
|---|
No analytics yet
Send a link to your students to track their progress
Wash hands thoroughly when ____
enter and exit the laboratory
All items that you incubate or refrigerate must be properly labeled with ____
Your name(s)
Incubation temp
The section code for the section you normally attend (MW10, MW1130, TTh1130, etc.)
Group
the contents (media, bacteria, treatment)
How to dispose slides?
place in cans on the ends of benches
How to dispose plates and gloves?
place in Biohazard waste container
How to dispose plastic pipettes?
In Biohazard waste container.
How to dispose test tube?
Place upright in racks in 'test tube disposal' tub on the counter in rm. 212
How to dispose broken glass?
Place in glass waste disposal
What is an exception for glass waste going in glass waste disposal?
Glass waste that is hazardous (e.g. mercury thermometers) or biohazard (e.g. inoculated test tubes) cannot be disposed of in that box
How to dispose paper waste?
place in regular trashcan UNLESS it is suspected to have contacted biological material
Any non‐glass material directly contaminated with live bacteria should be placed
In a biohazard bag.
Never enter a teaching lab without a teaching assistant present or leave a lab without the teaching assistant's knowledge and permission
TRUE or FALSE
TRUE
All hazardous chemicals must be handled in the ____.
Fume hood
Biosafety levels range from
BSL-1 (microbes not known to cause disease) to BSL-4 (lethal pathogens for which no vaccine or treatment exists)
Each biosafety level builds on the
Controls of the level before it
This laboratory is designated as a
BSL-2 lab
Why is this lab a BSL-2 lab?
Both BSL‐1 and BSL‐2 strains are used in lab exercises
Every microbiology laboratory, regardless of biosafety level, follows what?
Standard microbiological practices.
Standard Microbiological Practices are those that ____
Are those practices that are common to all laboratories.
Standard Microbiological Practices includes:
Not eating, drinking, or applying cosmetics in the lab
Washing hands after working with infectious materials and before leaving the lab
Routinely decontaminating work surface
BSL‐1 Microbes description
The microbes there are not known to consistently cause disease in healthy adults and present minimal potential hazard to laboratorians and the environment.
Specific considerations for a BSL‐1 laboratory include the following:
• Standard microbiological practices are followed.
• Work can be performed on an open lab bench or table.
• Personal protective equipment, (lab coats, gloves, eye protection) are worn as needed.
• A sink must be available for hand washing.
• The lab doors: separate the working space with the rest of the facility
BSL‐2 microbes used
The microbes pose moderate hazards to laboratorians and the environment.
The microbes are typically indigenous and associated with diseases of varying severity
An example of a microbe that is typically worked with at a BSL‐2 laboratory is
Staphylococcus aureus
An example of a BSL‐1 microbe that is typically worked with is
A nonpathogenic strain of E. coli
In addition to BSL‐1 considerations, BSL‐2 laboratories have the following containment requirements:
• Access to the laboratory is restricted when work is being conducted.
• Appropriate personal protective equipment (PPE) is worn, including lab coats and gloves. Eye protection and face shields can also be worn, as needed.
• All procedures that can cause infection from aerosols or splashes are performed within a biological safety cabinet .
• An autoclave or an alternative method of decontamination is available for proper disposals.
• The laboratory has self‐closing doors.
• A sink and eyewash are readily available
what factors would (or would not) influence growth and how the growth might appear on solid media
warmth, moisture, pH, and O2
colonies form
what is slant media used for?
Long term maintenance of isolates
what is liquid media used for?
For growth studies or biochem analysis
what is solid media is used for?
To obtain isolated colonies
Acidic dyes characteristics
nigrosin, eosin
background of cell is stained
negative chromatophores
Basic dyes characteristics
crystal violet
cell is stained
positive chromatophores
what does a heat fix do?
dries out cell wall and opens cells to dyes
helps cell stick to slide
kills the microorganisms
preserves the overall shape (morphology)
simple stain:
highlights cells to observe morphology and structures
only uses one staining agent
heat fixing
basic dye: positively charged -> attracted to negatively charged cells
When does one use negative staining? How is this method performed? With what kind of stain?
when determining morphology and cellular arrangement
without heat-fixing or harsh chemicals that distort delicate, capsule-producing, or difficult-to-stain microbes.
It works by using acidic, negatively charged dyes (e.g., Nigrosin, Indian Ink, Eosin) that are repelled by the negative surface of bacteria, staining the background dark while leaving cells clear.
Gram-postive characteristics
higher content of peptidoglycan and cross-linkage
allows for retention of primary stain and resists decolorization
Gram-negative characteristics
less peptidoglycan, higher lipid content
decolorization w/alcohol extracts lipids increasing porousness of cell
results in loss of primary stain
What was the objective of the Ubiquity of Microorganisms and growth of bacteria on solid and liquid media types lab?
• To show ubiquity of microorganisms: microbes are found everywhere! You will culture microbes on solid growth media by exposing plates to air, touch with fingertips, etc.
• To view patterns of bacterial growth on different forms of growth media: plates, slants, broth
• To understand the purpose for each growth media type
• Use proper terminology for characterizing growth on each media type
Where are Microbes Found?
Everywhere!
They are ubiquitous & diverse
Collectively, microbes are ubiquitous, but individual species may be found only in certain ____
locales
Aseptic technique are used to ___
prevent contamination because of the ubiquity of microorganisms
What types of microorganisms will likely be isolated on the plates, in the lab for Ubiquity of Microorganisms?
bacterial spores, fungal spores in the air, bacteria carried on dust particles
What will not likely be isolated on the plates, in the lab for Ubiquity of Microorganisms?
protozoan types.
Microbe types
free‐living
symbiotic ‐ parasitic
mutualistic, or commensal
pathogenic/non‐pathogenic
opportunistic pathogens
Commensalism definition
A relationship between two organisms in which one organism benefits and the other is unaffected
Opportunistic pathogens definition
normal microbiota that cause disease under certain circumstances
Why incubate at 25°C & 37°C?
because just like humans most bacteria have optimum temp at body temp of 37°C
Studying bacteria requires isolating desired bacterial species from environmental samples containing ____.
mixed cultures
Culturing Bacteria definition
Growing microorganisms in some type of growth media
Employ aseptic technique is used to ___.
to minimize contamination
Culture media types
Liquid
Solid
Liquid media is used for ____.
growth studies or biochemical analysis
Solid media is ____.
liquid media containing solidifying agent (agar)
Which type is optimum for obtaining pure cultures?
Solid media (agar)
Flat, convex, or raised is descriptions of _____
the colony elevation
Uniform fine turbidity definition
evenly cloudy throughout

Pellicle growth definition
bacterial type forming a thick floating mass of cells on the surface of a liquid culture

Sediment definition
mass of bacterial cells settling at the bottom of a liquid culture tube
The results of lab exercise 2-1 shown below are, among others, the reason why
a. hand washing is important
b. Disinfecting lab countertop is needed
c. Aseptic techniques were discovered
d. All of above
d. All of above
When growing bacteria, the choice of solid media (agar slant or agar plate) or liquid media depends on what you wish to accomplish; each of the three types is best suited for a particular purpose. Evaluate the following and choose the one which is incorrect; i.e., the medium type does not match its correct function.
A. best for pure culture determination: solid - agar slant medium
B. best for obtaining/harvesting lots of cells: liquid medium
C. best for obtaining isolated colonies: solid - agar plate medium
D. best for growth studies or DNA/protein isolation: liquid medium
A. best for pure culture determination: solid - agar slant medium
Best medium for pure culture determination
Solid agar
Best medium for harvesting
Liquid
An environmental (soil) sample obtained from a temperate region was transferred to a liquid growth medium and incubated at 30°C for 24 hours, then transferred to solid growth medium in order to isolate bacteria from the original sample. Following 48 hour incubation at 30°C, the picture of the solid medium shows the results of this experiment. Which of the following statement(s) among A - C are true regarding this experiment?
A. This plate represents a pure culture.
B. Isolates A and B are likely the only bacterial types that would have been present in the original environmental sample.
C. A and B are the same organism
E. NONE of A - C are correct
E. NONE of A - C are correct

Colony size, color, and shape are important factors used to describe bacterial growth. What other physical factor should be included in the description since it can influence the growth characteristics?
a. Incubation temperature
b. Duration of incubation
c. Type of growth medium used
d. All the above should be included as part of the description of bacterial growth
D. All the above should be included as part of the description of bacterial growth.
A mixed culture does not necessarily indicate a contaminated culture.
TRUE or FALSE
TRUE
Condenser lens
Has a numerical aperture value that contributes to resolution.

100X objective lens is used with _____ ____
immersion oil
Scanning objective lens has what level of magnification power? (Highest or lowest)
lowest

Iris diaphragm function
controls the amount of light entering the lens system of a microscope

Scanning lens (4x, 10x, 40x, 100x?)
4x
Low power lens (4x, 10x, 40x, 100x?)
10x
High-dry lens (4x, 10x, 40x, 100x?)
40x
Oil immersion lens (4x, 10x, 40x, 100x?)
100x
The limit of resolution of the 40X objective lens of your microscope is determined to be 360 nanometers. Will you be able to distinguish two points that are 365 nanometers apart or will they blur into one?
A. They will blur into a single point.
B. One cannot determine this from the information given.
C. They will be seen as two separate points very close together.
D. none of the above
C. They will be seen as two separate points very close together.
Which statement is true regarding prokaryotic cells, eukaryotic cells, and viruses?
A. There are two major taxonomic groupings (domains) of prokaryotes.
B. You would expect the size of Coronavirus to be in the 1 to 10 micrometer range.
C. Prokaryote cells are generally more complex and larger than eukaryotic cells.
D. Within domain Eukarya, yeasts, algae, protozoans, and archaea are representative types of microorganisms.
E. Two of the above are true.
A. There are two major taxonomic groupings (domains) of prokaryotes.
Why is it important to center an object you are analyzing in the field of view of the microscope before switching to a higher power lens?
A. As magnification increases, the field of view decreases and objects at the periphery will no longer be in the visible field.
B. The lens has good resolving power only in the absolute center of the field of view.
C. The curvature of the lens will severely distort objects that are not in the center of the field of view.
D. The light source illuminates only the center of the field of view.
A. As magnification increases, the field of view decreases and objects at the periphery will no longer be in the visible field.
Most microscopes are parfocal. This means that the distance from the nosepiece opening to the focal plane of each lens has been standardized. What does this mean to you with regard to how you use the microscope?
A. When the specimen is in focus, the slide will always be the same distance away from the end of the lens no matter which lens is being used.
B. Once the specimen is in focus under a low-power lens, the microscope can be switched to a higher-power lens without moving the stage and the image will be in or nearly in focus no matter what lens is used.
C. All lenses will need to be used the same way, either through air or through oil.
D.It means you never need to adjust the amount of light coming in.
B. Once the specimen is in focus under a low-power lens, the microscope can be switched to a higher-power lens without moving the stage and the image will be in or nearly in focus no matter what lens is used.
Which is a false statement among A - C regarding the oil immersion technique?
A. it is generally required for viewing prokaryotic cells in order to make the most accurate observations of cell morphology and arrangement.
B. immersion oil is placed directly on top of the specimen to be viewed
C. if paired with a 10X ocular lens, it would allows for a maximum total magnification of around 100X
D. A, B, C are all true statements
C. if paired with a 10X ocular lens, it would allows for a maximum total magnification of around 100X
Imagine you are now physically in the lab. You have finished up that day's lab and during the course of the lab you:
Washed/dried hands and threw the used paper towel in the regular trash.
Spilled a drop of E coli culture on the bench and wiped up with a paper towel, then threw it in the regular trash.
Disposed of your used plate culture in the biohazard waste container.
Threw your used microscope slide in the broken glass container.
Which of 1 - 4 above does not represent the proper disposal of waste in the microbiology lab?
A. Number 1
B. Number 2
C. Number 3
D. Number 4
E.Numbers 1 - 4 are all proper protocols
B. Number 2
If you are enrolled in a Monday laboratory section and miss a class one Monday during the semester, you can generally make up that the missed lab exercises by performing them during your Wednesday lab session of the same week.
True or False
False
You changed the light source of a light microscope to a bigger wattage bulb to increase light intensity. You have now dramatically increased the resolution of that microscope.
True or False
False
Aseptic technique means that that you perform the preparation of media or the transfer of living microbes
A. under completely sterile conditions.
B. without introducing contamination.
C. uniformly and consistently.
D. only with pathogens.
E. in a specialized chamber
B. without introducing contamination.
Basic growth media must be formulated to meet the diverse nutritional requirements of routinely cultivated bacteria, which includes supplying sources of ____________ and nitrogen in various forms. If these nutrients are supplied in the form of animal extracts like peptone or beef extract, the growth medium is termed a _______________ medium.
A. oxygen; defined
B. agar; complex
C. carbon; defined
D. yeast extract; defined
E. water; complex
F. carbon; complex
F. carbon; complex
If you performed a quadrant streak plate and obtained the result shown in "A" rather than the desired result shown in "B", then you probably...
A. forgot to inoculate each new quadrant with fresh culture.
B. forgot to flame the wire inoculation loop between quadrant streaks
C. forgot to streak into the previous quadrant.
D. used the wrong culture for streaking the plate.
E.forgot to streak with your loop in one continuous motion.
B. forgot to flame the wire inoculation loop between quadrant streaks

This method for preparing a streak plate is really only used when one wants to obtain isolated colonies from a bacterial culture of very low cell density.
A. spot-inoculation method
B. zig-zag method using a sterile swab
C. quadrant method using a wire loop
D. none of the above
B. zig-zag method using a sterile swab
Which of the following choices describes a negative stain?
A. Use an acidic stain and basic stain combination to produce dark-stained cells in a light-stained background
B. Use an acidic stain to yield un-stained cells in a dark-stained background
C. Use an acidic stain and basic stain combination to reveal light-stained cells in a dark-stained background
D. Use a basic stain to give un-stained cells in a dark-stained background
B. Use an acidic stain to yield un-stained cells in a dark-stained background

The cellular morphology and arrangement of this bacterial species would best be described as
A. bacillus
B. streptococcus
C. tetrads
D. streptobacillus
E. Pleomorphic
D. streptobacillus
Which of the following is not part of the proper protocol for performing a simple stain?
A. If a plate culture is your source of bacteria, make sure to mix the bacterial sample in a drop of water
B. Make sure to air dry the smear before passing through a flame
C. Use aseptic technique when transferring bacteria to the slide
D. Make sure you have a large sample of cells to prepare a very dense, thick smear
E. Cover the smear with a basic stain for a minute, rinse, then blot dry
F. All the above are proper steps to perform a simple stain
D. Make sure you have a large sample of cells to prepare a very dense, thick smear
If a particular bacterial species has a cellular morphology described as "pleomorphic", then
A. it must be of uniform shape and size.
B. it is considered a streptobacilli.
C. it probably consists of irregular forms, branching forms, and non-uniform cells.
D. it is a spirochete.
E. it is a combination of tetrads and cocci.
C. it probably consists of irregular forms, branching forms, and non-uniform cells.
During the simple stain procedure, why is it necessary to heat-fix the cells?
A. To kill them.
B. To dry them out.
C. To adhere them to the slide.
D.To make them permeable to stain.
C. To adhere them to the slide.

The following represent the results of two staining protocols. Which has been stained with nigrosin?
A. Stain A
B. Stain B
C. Neither stain A or stain B
D. Both stain A or stain B
A. Stain A

Bacillus shape description
Rod shaped bacteria

Streptococcus shape description
Berry - shapped bacterium found in twisted chains.

Tetrads shape description
4 cocci in a square

Streptobacillus shape description
chain of rods

Pleomorphic bacteria shape description
bacteria that can take on different shapes, due to their heredity

Monococcus shape description
a single spherical bacterial cell.


Upon completion of the acid-fast stain, cells with mycolic acid in their cell envelope will appear
A. blue
B. black
C. reddish-purple
D. Green
C. reddish-purple
In the acid-fast staining procedure, if you over-decolorized cells during the application of acid-alcohol then ...
A. all the cells would appear blue.
B. all the cells would appear green.
C. all the cells would appear reddish-purple
D. none of the cells would be stained;
A. all the cells would appear blue.
Differential stains function to
A. kill certain cells while allowing others to remain alive.
B. stain all cell types the same.
C. differentiate between bacteria and archaea.
D. highlight/distinguish differences between cell types and/or parts of a cell.
E. Two of A - D are correct.
D. highlight/distinguish differences between cell types and/or parts of a cell.

Regarding the Gram stain procedure: whether Gram-positive or Gram-negative, cells may appear colorless...
A. prior to application of the primary stain
B. prior to application of the counterstain
C. following application of the mordant
D. A, B, and C are all true
E. Only A and B are true
F. Only B and C are true
E. Only A and B are true
A. prior to application of the primary stain
B. prior to application of the counterstain